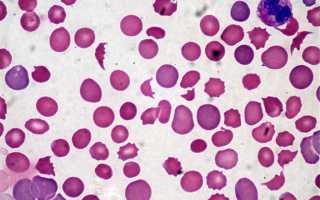
Синдром мошковица что это такое

Болезнь Мошковица является острым, скоротечным заболеванием, для которого характерна тромбоцитопения наряду с гемолитической анемией. Прочие проявления могут в себя включать изменение сознания в сочетании с почечной недостаточностью. Для проведения диагностики нужно выполнение лабораторных тестов, которые демонстрируют характерные нарушения, гемолитическую отрицательную анемию в том числе. Для терапии синдрома Мошковица применяется замещение плазмы наряду с кортикостероидами для взрослых пациентов и поддерживающим лечением для детей (порой включающим гемодиализ). Что касается «Экулизумаба», таковой назначается редко.
О патологии
Тромботическая тромбоцитопеническая пурпура выступает крайне тяжелой окклюзивной микроангиопатией, которая характеризуется процессом системной агрегации тромбоцитов. В случае формирования этой патологии у пациентов отмечается ишемия различных органов наряду с выраженной тромбоцитопенией и гемолитической микроангиопатической анемией. Далее рассмотрим, каковы причины развития этого отклонения у взрослых и детей. Также расскажем о клинических рекомендациях при болезни Мошковица.
Причины появления патологии у детей
Большинство случаев болезнь Мошковица у детей сопровождается геморрагическим колитом, который возникает в результате воздействия токсинпродуцирующих бактерий. Также возбудителем может выступать шигелла. В отношении маленьких пациентов целесообразно применять поддерживающую терапию при гемолитической анемии у детей.
Факторы, влияющие на появление болезни у взрослых
У взрослых пациентов болезнь Мошковица часто имеет неясное происхождение. Известные причины, как правило, включают:
- Влияние иммунодепрессивных средств (например, «Циклоспорина») и противоопухолевых химиотерапевтических препаратов («Митомицин»).
- Наличие беременности (часто неотличима от развития тяжелой эклампсии).
- Развитие геморрагического колита, возникшего в результате воздействия кишечной палочки.
Предрасполагающими факторами для многих пациентов служит врожденная или приобретенная форма дефицита особых ферментов кровяной плазмы, которые должны расщеплять и устранять аномальные мультимеры, способные вызвать тромбоцитарные сгустки. Теперь расскажем о факторах проявления рассматриваемой патологии и вариантах ее симптоматики.
Симптомы у взрослых и детей
Проявление патологии развивается с разной степенью тяжести сразу в нескольких органах. Эти симптомы включают обычно слабость наряду со спутанностью сознания или комой, болью в животе, тошнотой, рвотой, диареей и аритмией, вызванной повреждением миокарда. У детей часто появляется рвота с болями в животе, поносом (часто кровавым). Может подниматься температура с ознобом, что указывает на сепсис.
Диагностика
В рамках диагностики болезни Мошковица назначаются такие анализы:
- Сдача крови на определение состояния тромбоцитов, проведение антиглобулинового теста, установление лактатдегидрогеназы, выяснение протромбинового и тромбопластинового времени.
- Исключение прочих тромбоцитопенических патологий.
- Тромботическую пурпуру подозревают среди пациентов с характерной симптоматикой анемии и тромбоцитопении. При подозрении этого недуга больному надо назначать ряд исследований наподобие анализа мочи, мазка периферической крови, выяснение объема ретикулоцитов, изучение сыворотки ЛДГ, оценивание функций почек, сывороточного билирубина (прямого и непрямого) и теста Кумбса.
Подтверждают диагноз следующие показатели:
- Развитие тромбоцитопении и анемии.
- Появление фрагментированных эритроцитов в мазке периферической крови обычно свидетельствует о развитии микроангиопатического гемолиза (при этом наблюдаются шлемовидные, треугольные и деформированные эритроциты).
- Присутствие признаков гемолиза (в форме понижения уровня гемоглобина, полихромазии, повышенного количества ретикулоцитов, зашкаливающего значения ЛДГ и билирубина, уменьшение гаптоглобина).
- Отрицательные значения прямого антиглобулинового теста.
В противном случае необъяснимая форма тромбоцитопении и гемолитической анемии выступает достаточным основанием для установления предположительного диагноза.
Несмотря на то что среди некоторых пациентов основные причины (к примеру, «Циклоспорин») или взаимосвязь с чем-либо (допустим, с наличием беременности) очевидны, среди большинства людей тромботическая пурпура появляется внезапным и самопроизвольным образом, без видимых оснований.
В отношении детей с диареей, а также взрослых, имеющих продромальные проявления геморрагического поноса, проводят анализ стула (речь идет об иммуноферментном исследовании на шигатоксины или специальную культуральную среду). Правда, к моменту взятия анализа организм больного может полностью очиститься от микроскопических организмов и токсинов. Далее выясним, как проводится лечение.
Лечение
Предпринимаются, как правило, следующие варианты терапии тромботической тромбоцитопенической пурпуры:
- В отношении взрослых проводится плазмаферез и прием кортикостероидов.
- Детям с этой патологией выполняют поддерживающее лечение, часто включающее гемодиализ.
- При наличии рефракторной атипичной формы назначают «Экулизумаб».
Типичный, связанный с диареей, рассматриваемый недуг у детей, который вызван энтерогеморрагическими инфекциями, обычно самопроизвольно может прекращаться и лечится посредством поддерживающих методик без использования антибиотиков или плазмафереза. Стоит отметить, что более чем половине больных обычно требуется гемодиализ. Не вылеченная тромбоцитопеническая тромботическая пурпура почти всегда заканчивается для пациентов летальным исходом. Но с помощью применения плазмафереза более восьмидесяти пяти процентов больных полностью выздоравливают.
Читайте также: Судорожный синдром алкогольной этиологии характеризуется
Замещение плазмы врачи, как правило, продолжают проводить каждый день, вплоть до полного исчезновения признаков активной формы заболевания. Основным индикатором этого является нормальное число тромбоцитов. Замещение плазмы занимает от нескольких дней до пары-тройки недель. Взрослым с этим диагнозом также назначаются кортикостероиды. Для больных, у которых отмечаются рецидивы, могут оказаться эффективными более интенсивные препараты с ритуксимабом.
Большинство пациентов испытывают только один эпизод этого недуга. Но тем не менее рецидивы наблюдаются приблизительно у сорока процентов пациентов. При этом у них отмечают серьезный дефицит активности фермента ADAMTS13, что вызвано ингибитором аутоантител. Таких больных нужно очень быстро обследовать, особенно когда симптоматика указывает на развитие рецидива.
У тех людей, которые восприимчивы к заместительной терапии посредством плазмы или воздействию кортикостероидами и с прогрессирующей формой заболевания, дополнительное ингибирование с применением «Экулизумаба» порой может полностью обращать почечную недостаточность. Дети с предполагаемым дефицитом регулирующего белка особенно склонны реагировать на использование «Экулизумаба».
Считают целесообразным раннее назначение антикоагулянтной терапии, поскольку в патогенезе заболевания ведущая роль отводится диссеминированному внутрисосудистому свертыванию. Бернсток и Хирсон (L. Bernstock, С. Hirson, 1960 г.) отмечают ремиссии при лечении гепарином, причем чем раньше начато лечение, тем благоприятнее результаты. Кваан (H. С. Kwaan, 1968 г.) рекомендует использовать стрептокиназу. Широкое распространение нашли дезагреганты (ацетилсалициловая к-та, дипиридомол).
Гепарин-индуцированная тромбоцитопения (ГИТ) — форма тромбоцитопении, вызываемая применением «Гепарина», который широко используется в клинической практике с целью профилактики и лечения тромбозов.
«Гепарин»
Антикоагулянт прямого действия, относится к группе среднемолекулярных гепаринов, замедляет образование фибрина. Цена «Гепарина» будет представлена ниже.
Показания: тромбозы, тромбоэмболии (профилактика и лечение), предупреждение свертывания крови (в сердечно-сосудистой хирургии), тромбозы коронарных сосудов, диссеминированное внутрисосудистое свертывание крови, послеоперационный период у больных с тромбоэмболиями в анамнезе. Профилактика свертывания крови во время операций с использованием экстракорпоральных методов кровообращения.
Цена «Гепарина»
В нашей стране стоимость во многом зависит от формы и дозирования. В связи с этим ценовой диапазон очень широк и колеблется от сорока до полутора тысяч рублей.
«Стрептокиназа»
Действующим веществом этого медикаментозного средства выступает стрептокиназа. Производят лекарство в виде порошка, который является основной для приготовления инъекции, предназначенной для капельного внутривенного, а порой и для внутриартериального ввода. Производят средство во флаконах с различной дозировкой: начиная от 100 000, заканчивая 1 500 000 ИЕ (единицами измерения количества вещества).
Показания к использованию «Стрептокиназы»
Назначается препарат для лечения эмболии (то есть с целью устранения закупорки) легочных артерий и ее ветвей. Применяется средство и для лечения тромбоза (когда образуются сгустки крови в сосудах), при блокировке артерий периферии. Целесообразно его применение и на фоне развития венозного тромбоза глубоких и находящихся близко к кожным покровам протоков. Не менее эффективен представленный медикамент в рамках лечения острой формы инфаркта миокарда в первые двенадцать часов и при поражении сосудистых сеток.
Это средство может активировать ферментную фибринолитическую систему, которая способна растворять сгустки, расщеплять фибрин, содержащийся в тромбах в вене. Собственно благодаря этому и растворяются кровяные сгустки, закупорившие сосуды (проявление тромболизиса).
Противопоказания
Запрещено использовать рассматриваемый медицинский препарат при развитии геморрагического диатеза, на фоне кровотечения, высокого давления, стрептококкового сепсиса, язвы желудка, септического эндокардита, тяжелых форм диабета. Следует с осторожностью назначать средство при тяжелом поражении почек и в случае туберкулеза в активной фазе.
«Стрептокиназа»: инструкция по применению
Лекарство «Стрептокиназа» вводят капельно (то есть внутривенно и внутриартериально), разводят препарат, как правило, в растворе хлорида натрия. Стартуют обычно с небольших дозировок (250 тысяч ИЕ) на 50 миллилитров раствора, в течение получаса. После этого запускается лизис (процессы рассасывания тромбов в вене). Затем вводится по 100 тысяч вещества в час, в течение шестнадцати-восемнадцати часов. В артерию этот лечебный препарат вводится при острой форме инфаркта, начиная с 20 тысяч единиц.
Чем раньше терапия «Стрептокиназой» начнется, тем быстрее, а вместе с тем и эффективнее будет достигнуто растворение тромба. Нежелательно использовать это средство в том случае, если инфаркт миокарда возник более двадцати четырех часов назад. В течение и после лечебной процедуры необходимо проконтролировать тромбиновое время больного (то есть скорость сворачивания крови) и содержание нейфибриногена.
Читайте также: Адреногенитальный синдром у новорожденных причины
Наступление передозировки, как правило, маловероятно. Теоретически таковая может вызывать понижение свертываемости крови у пациентов.
Стоит отметить, что у пациентов может возникнуть нестандартная реакция в виде тошноты, озноба или гематомы. В целях предотвращения подобной реакции рекомендуют вводить медицинское средство под названием «Преднизолон» в количестве 50 миллиграмм.
Условия и сроки хранения
Лиофилизат с препаратом «Стрептокиназы» способен сохранять свое лечебное свойство сроком до пяти лет при условии соблюдения рекомендаций по хранению, которые требуют следующее: держать препарат вдали от прямого попадания лучей солнца. Температура среды должна быть не больше двадцати градусов. Приготовленный раствор хранится не больше двенадцати часов.
В 1925 году Б. Мошковиц описал тяжелый острый синдром, характеризующийся постоянным сочетанием тромбоцито пенической пурпуры с гемолитической анемией и неврологическими проявлениями.
Этиопатогенез синдрома Мошковица.
Причина синдрома не уточнена, но, по-видимому, ряд исследований доказал инфекционную природу синдрома, возбудителем которого является менингококк. Ввиду клинико-биологического сходства, синдром Мошковица приближается к коллагенозам, с которыми он часто сочетается (в особенности с рассеянной эритематозной волчанкой и узелковым периартериитом).
Частота (статистика) синдрома Мошковица.
Синдром Мошковица встречается в любом возрасте (даже у грудного и новорожденного ребенка), но чаще всего у людей между 25 и 50 годами. Он одинаково поражает оба пола. Число описанных случаев не велико. Согласно статистике опубликованной в 1968 г., отмечалось 300 случаев. Но с тех пор число диагностированных случаев значительно возросло.
Множество синонимов обозначает ту же клиническую картину синдрома Мошковица:
- тромботическая тромбоцитопеническая пурпура;
- симптоматический комплекс Мошковица – Сингера;
- тромботическая микроангиопатия;
- тромбоцитопения Саммерса;
- острая плейохромная анемия;
- синдром Мошковица – Сингера – Саммерса;
- тромбогемолитическая тромбоцитопеническая пурпура;
- общий капиллярный и артериальный тромбоз;
- лихорадочная острая анемия с тромбоцитопенической пурпурой и сосудистым тромбозом;
- тромбозирующий акроангиотромбоз;
- рассеянный тромбоцитопенический тромбоз;
- тромбозирующий тромбоцитный синдром;
- тромбозирующая микроангиотромботическая гемолитическая анемия.
Симптоматология синдрома Мошковица.
Клиническое начало обычно проявляется внезапно, вне зависимости от возраста.
Вначале появляются неспецифические общие клинические признаки:
- невысокая температура,
- анорексия,
- астения,
- миалгии,
- артралгии.
Позже, устанавливаются специфические признаки синдрома:
Сердечно-сосудистые проявления:
- тахикардия,
- галопообразный ритм и систолический шум в очаге выслушивания митрального клапана.
Геморрагические признаки:
- пурпура;
- кожные петехии или кровоподтеки;
- кровоточащие десны;
- гематурия;
- метроррагии;
- мелена или гематемезис.
Дигестивные проявления:
- рвота желчью или кровью;
- гепато- и спленомегалия;
- легкая желтуха.
Почечные признаки:
- олигурия,
- острая почечная недостаточность с задержкой азота.
Неврологические признаки.
Они появляются рано и протекают очень тяжело. Своим тяжелым течением приводят к мысли о наличии какого-нибудь менингита или подарахноидального кровоизлияния. Постоянно неврологические нарушения сочетаются или даже обусловливают появление некоторых значительных психических расстройств.
Так у больных могут проявляться:
- головные боли;
- атаксия мозжечка;
- афазия;
- парезы или спастические параличи, обычно односторонние;
- нарушения поля зрения или слепота;
- тонико-клонические конвульсии;
- нарушения сознания;
- летаргия;
- ступор;
- туманное состояние;
- бред;
- кома.
Диагностика синдрома Мошковица.
Лабораторные обследования предоставляют важные данные для точного диагноза, а именно:
- значительную тромбоцитопению (число тромбоцитов обычно ниже 100 000/мм3); число их снижается во время острого приступа, а затем снова возрастают (но никогда до нормальной величины) в периоды ремиссии;
- время кровотечения — повышенное;
- гемолитическую анемию; в периферической крови, при пониженном числе эритроцитов, появляется множество скизоцитов и сфероцитов;
- миелограмма выявляет присутствие множество мегакариоцитов и гиперплазию эритроцитов;
- дисглобулинемию (непостоянно), всегда с нарастанием плазматических гаммаглобулинов;
- задержку азота (мочевина в крови увеличивается, совместно с установлением острой почечной недостаточности); альбуминурию; время свертывания и время протромбина всегда нормальное.
Электроэнцефалограмма (ЭЭГ) выявляет чаще всего рассеянное поражение мозга и только изредка его очаговые поражения. Но описаны и случаи, при которых мозговая электроактивность нормальная.
Анатомопатологическое обследование при синдроме Мошковица.
Систематический патологоанатомический анализ часто способствует распознаванию случаев синдрома Мошковица, диагноз которых не был поставлен прижизненно.
Основное поражение – это микроангиопатии на месте соединения атериол с капиллярами, с подэндотелиальным отложением гиалинового, ацидофильного материала. Недавно проведенные исследования установили природу этого вещества, доказав, что оно принадлежит к мукополисахаридам и состоит из сочетания гиалуроновой и хондроитинсерной кислоты с некоторыми протеинами.
Пораженный эндотелий создает гнезда, в которых откладываются тромбоциты, способствуя, таким образом, выключению из кровообращения.
Тромботические поражения имеются во всей сосудистой системе, но локализуются предпочтительно на уровне миокарда, почек, поджелудочной железы, надпочечников и серого вещества мозга.
Течение и прогноз синдрома Мошковица.
Приблизительно в 80% случаев течение быстро ведет к смертельному исходу, в течение нескольких дней или недель от начала заболевания. В остальных 20% случаев, течение подострое или даже хроническое с периодами ремиссии. В этих случаях смерть наступает обычно через 6 месяцев после начала болезни.
Прогноз синдрома Мошковица — неблагоприятный. Исключительно редко больные могут прожить несколько лет.
Лечение синдрома Мошковица.
Лечение — в общем, неудовлетворительное и все же, подходящее лечение, быстро и правильно примененное, может привести к ободряющим результатам, хотя во всех случаях они только временные.
В зависимости от случая, рекомендуется обыкновенная кортикотерапия, сочетающаяся с переливанием крови или с удалением селезенки. В некоторых случаях, гепарин совместно с обменозамещающим переливанием крови.
Кортикотерапия в дозе 2 мг/кг веса тела/день перорально, благоприятно влияет на гематологические и геморрагические проявления, без того, однако, чтобы повлиять на смертельный исход.
Переливание крови и даже обменнозамещающее переливание крови не оказывает длительного влияния на существующую анемию.
Удаление селезенки, произведенное как можно ближе к началу болезни, влияет положительно на гемолитический компонент анемии.